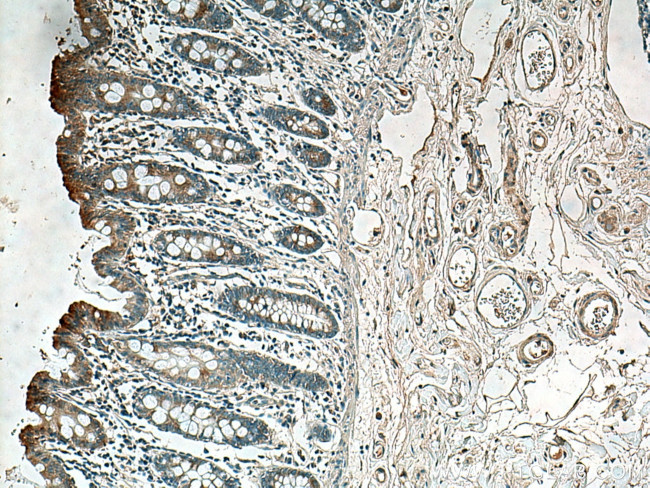
ACADL Antibody in Immunohistochemistry (Paraffin) (IHC (P))

Search
Proteintech
ACADL Polyclonal Antibody
{{$productOrderCtrl.translations['antibody.pdp.commerceCard.promotion.promotions']}}
{{$productOrderCtrl.translations['antibody.pdp.commerceCard.promotion.viewpromo']}}
{{$productOrderCtrl.translations['antibody.pdp.commerceCard.promotion.promocode']}}: {{promo.promoCode}} {{promo.promoTitle}} {{promo.promoDescription}}. {{$productOrderCtrl.translations['antibody.pdp.commerceCard.promotion.learnmore']}}
产品信息
17526-1-AP
种属反应
已发表种属
宿主/亚型
分类
类型
抗原
偶联物
形式
浓度
规格
纯化类型
保存液
内含物
保存条件
运输条件
产品详细信息
The size difference between the precursor and mature rat LCAD has been estimated to be 3 kDa on the basis of SDS-PAGE. Defects in ACADL are a cause of acyl-CoA dehydrogenase very long-chain deficiency (ACADVLD). This antibody is specific to ACADL.
靶标信息
The protein encoded by this gene belongs to the acyl-CoA dehydrogenase family, which is a family of mitochondrial flavoenzymes involved in fatty acid and branched chain amino-acid metabolism. This protein is one of the four enzymes that catalyze the initial step of mitochondrial beta-oxidation of straight-chain fatty acid. Defects in this gene are the cause of long-chain acyl-CoA dehydrogenase (LCAD) deficiency, leading to nonketotic hypoglycemia.
仅用于科研。不用于诊断过程。未经明确授权不得转售。
生物信息学
蛋白别名: acetyl-Coenzyme A dehydrogenase, long-chain; Acyl Coenzyme A dehydrogenase, long chain; acyl-Coenzyme A dehydrogenase, long chain; acyl-Coenzyme A dehydrogenase, long-chain; LCAD; LCAD long chain acyl-CoA dehydrogenase; long-chain acyl-CoA dehydrogenase; Long-chain specific acyl-CoA dehydrogenase, mitochondrial; Medium-chain acyl-CoA dehydrogenase, mitochondrial; unnamed protein product
基因别名: AA960361; ACAD4; ACADL; ACOADA; AU018452; C79855; LCAD
UniProt ID: (Human) P28330, (Mouse) P51174, (Rat) P15650
Entrez Gene ID: (Human) 33, (Mouse) 11363, (Rat) 25287